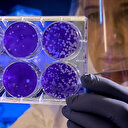

Tüm dünyayı kasıp kavuran koronavirüs nedeniyle hayatını kaybedenlerin sayısı artmaya devam ediyor. Henüz koronavirüse çare bulunamamışken Çin'de bunyavirüs adında yeni bir salgın ortaya çıktı. 7 kişinin öldüğü ve 60'tan fazla kişinin de hastaneye kaldırıldığı iddia edilen bunyavirüs nedir? Bunyavirüsün belirtileri nelerdir? Bunyavirüs ile ilgili detaylar haberimizde...
Taiwan News’te yer alan habere göre, kene kaynaklı yeni Bunyavirüsün Çin’de ortaya çıktığı ve 7 kişinin ölümüne, 60’tan fazla kişinin de hastaneye yatırıldığı açıklandı. Peki bunyavirüs nedir? Bunyavirüsün belirtileri nelerdir? Virüsle ilgili bilgiler ülkemizde de merak konusu oldu.
BUNYAVİRÜS NEDİR?
BUNYAVİRÜSÜN BELİRTİLERİ NELERDİR?
- Trombositopeni Sendromu (SFTS)’nin kuluçka süresi 7 ila 14 gündür ve yaygın semptomlar arasında ateş, halsizlik, bulantı, karın ağrısı ve iştah azalması bulunur.
Bunyavirales, negatif algılamalı tek sarmallı RNA virüslerinin bir sırasıdır. Ellioviricetes sınıfındaki tek düzendir. Eskiden Bunyaviridae virüs ailesi olarak biliniyordu. Bunyavirales (Bunyavirüs) adı, orijinal tip Bunyamwera orthobunyavirus türünün ilk keşfedildiği Bunyamwera’dan türemiştir.